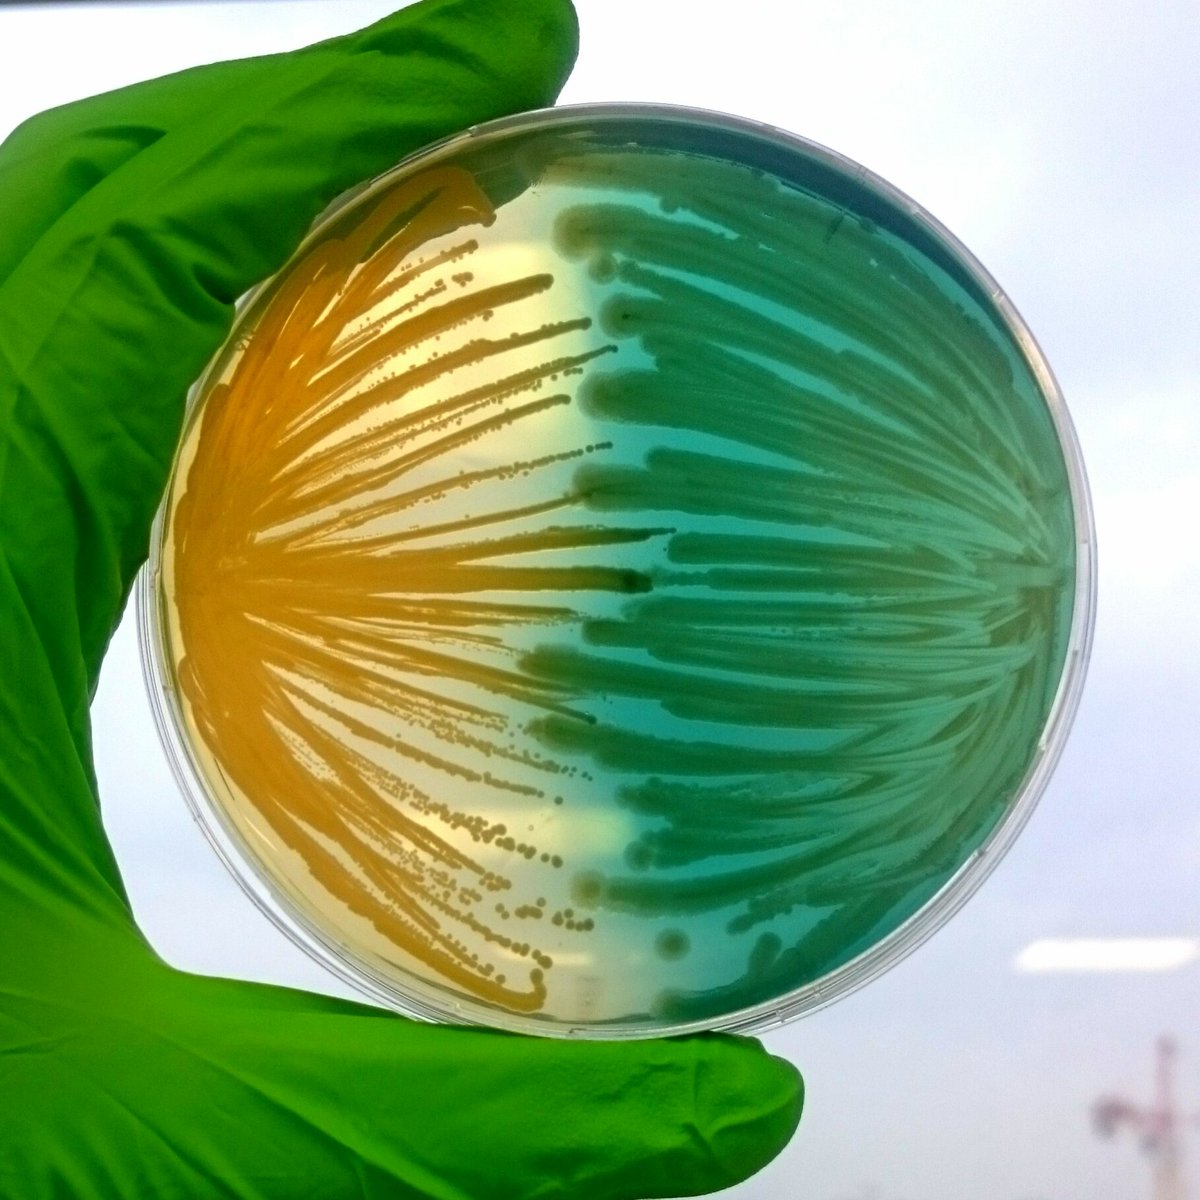
Today marks the end of more than 4 wonderful years in <a href="/CIRI_Lyon/">CIRI Lyon</a>, supervised by @KMoreauLyon and <a href="/VDE_Staph/">CIRI-Staph</a>. Many thanks to this very great team and all the people that supported me 🙌  It’s now time for new adventures… in Germany! 🇩🇪

CIRI-Staph
@vde_staph
team leader @VDE_Staph @CIRI_Lyon
ID: 982299313278566400
06-04-2018 16:49:41
73 Tweet
149 Followers
24 Following



a smart innovative approach to understand the dynamic of antibiotic resistance in the hospitals; take a look at : doi.org/10.7554/eLife.… eLife - the journal




The Early Career Scientist Symposium is kicking off tomorrow at 12pm EST with a career seminar from KCRiceUF followed by two sessions chaired by @DocAndreasHaag and Marta Zapotoczna featuring talks from @stephanie_marr, Jhih-Hang Jiang, Rachel Zapf, Xuhui Zheng, Laura Camus and more.